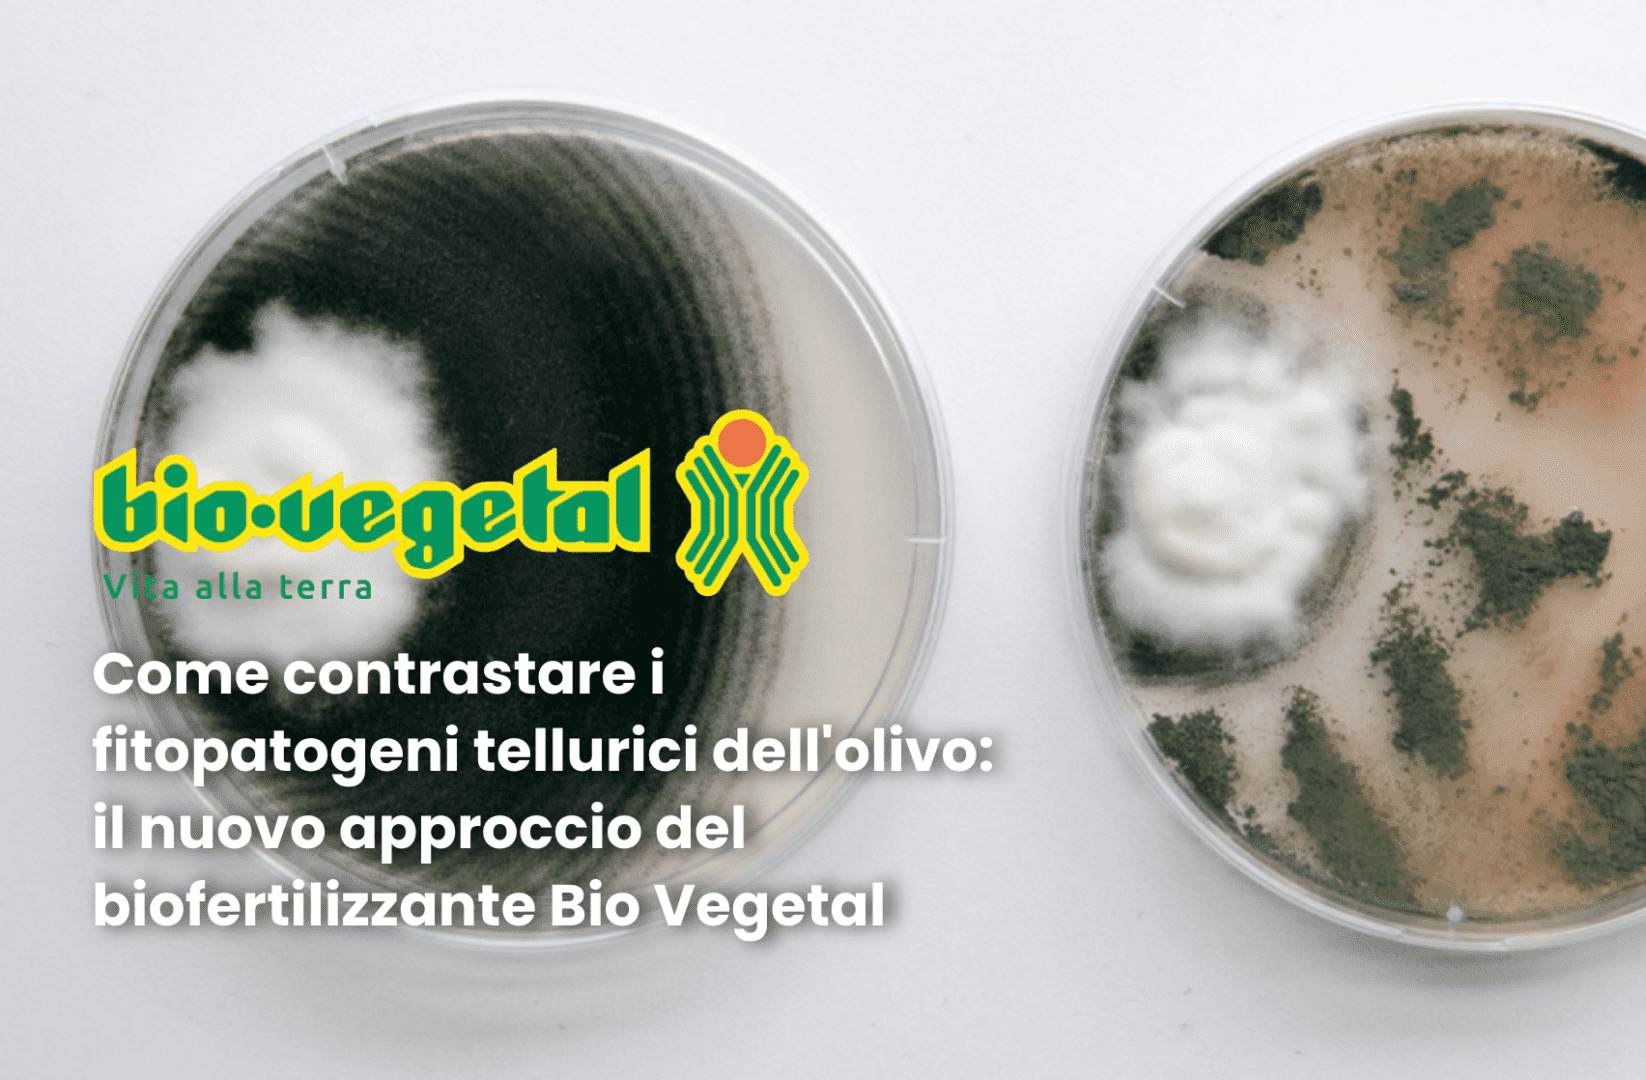
bio vegetal biofertilizzante olivo

L’utilizzo dei microrganismi “buoni” per contrastare quelli “cattivi” è una delle soluzioni più adatte al nuovo approccio all’agricoltura, determinato non solo dalla necessità di un’agricoltura più sostenibile, ma anche da obiettivi generali dell’Unione Europea, tracciati dal Grean Deal e dalla strategia Farm to Fork. In questa ottica Tersan Puglia ha voluto studiare, con la collaborazione dell’Università degli Studi di Bari, gli effetti dell’utilizzo di Bio Vegetal, biofertilizzante certificato per agricoltura biologica, nel contrasto di alcuni fitopatogeni tellurici di ampia diffusione.
La tesi, già sostenuta da un’ampia letteratura scientifica, è stata verificata nell’ambito del progetto di ricerca industriale Tersan 3, finalizzato alla realizzazione di innovazioni di processo, creazione di fertilizzanti smart e miglioramento qualità del prodotto finito.
L’aspetto dell’effetto soppressivo sviluppato grazie all’utilizzo di Bio vegetal è stato curato dai ricercatori di Tersan Puglia con il professor Franco Nigro, del dipartimento di Scienze del suolo, della pianta e degli alimenti dell’Università degli Studi di Bari Aldo Moro.
Lo studio per la realizzazione di Bio Vegetal, iniziato tre anni fa e tutt’ora in corso, si è concentrato su:
- Verticillium dahliae, patogeno che può creare danni notevoli soprattutto sulle piante più giovani in quanto produce strutture di resistenza estremamente piccole, da quindici a 150-200 micron visibili solo al microscopio, che possono sopravvivere nel terreno per tantissimo tempo, anche in assenza di una pianta ospite: i microsclerozi;
- Dematophora necatrix (Rosellinia necatrix), agente del marciume radicale lanoso, particolarmente distruttivo sulle piante più giovani;
- Armillariella mellea, fungo agente del marciume radicale fibroso molto pericoloso, che una volta insediatosi in un terreno risulta di difficile gestione.

Effetto del bioˑvegetal® sulla germinazione conidica di Verticillium dahliae.
Il biofertilizzante Bio Vegetal ha determinato una significativa riduzione della densità di inoculo dei microsclerozi di Verticillium dahliae già due giorni dopo il trapianto e nessun sintomo di disseccamento sulle piante. Bio Vegetal è stato aggiunto alle concentrazioni, rispettivamente, dell’1%, del 5% e del 10% del volume di terreno: le applicazioni all’1% sono risultate quelle più efficaci. Allo stesso modo, Bio Vegetal è stato applicato su suolo e in vasi in cui erano presenti microsclerozi di Verticillium dahliae: anche qui le applicazioni del biofertilizzante hanno determinato significative riduzioni della quantità dei microsclerozi presenti.
L’applicazione di Bio Vegetal ha al tempo stesso comportato l’attivazione della comunità microbica presente nel suolo, sia dei batteri totali coltivabili sia dei funghi filamentosi e dei lieviti. Le differenze sono risultate più significative un anno dopo il trattamento del terreno con il biofertilizzante all’1%. Inoltre, prove fatte con differenti concentrazioni (1%, 2,5% e 5%) di estratti acquosi di biofertilizzante hanno determinato significative riduzioni anche della germinabilità dei conidi di Verticillium dahliae.

Inibizione della crescita miceliale.
Le prove in campo sono state svolte sul patogeno Armillaria mellea in un oliveto in agro di Andria, mettendo a confronto diversi trattamenti.
In questo stadio della ricerca è emerso che l’altezza delle piante è significativamente più alta nei soggetti che sono stati trapiantati con il biofertilizzante Bio Vegetal. Si riscontrano, inoltre, significative differenze rispetto al testimone non trattato. Il risultato si è mantenuto costante da Ottobre 2018 fino all’ultimo rilievo, effettuato a Marzo 2021. Un dato ancora più interessante è l’ingrossamento del diametro del tronco, che nel testimone è rimasto intorno ai 2 cm, mentre nel caso trattato con Bio Vegetal ha raggiunto quasi i 3 cm.
L’attività fotosintetica è risultata – in base ai parametri studiati – significativamente più elevata nella tesi trattata con Bio Vegetal.
Infine, il dato più importante: quello relativo alla presenza del patogeno A. mellea nel terreno, determinato mediante Real time PCR. I risultati, all’inizio piuttosto deludenti nel novembre 2018, a circa un anno dall’inizio della prova; già a luglio 2019 si cominciava a vedere un comportamento diverso, per arrivare agli ultimi dati relativi a quest’anno, in cui appare evidente che i campioni di terreno prelevati dalla rizosfera delle piante testimone presentano una biomassa espressa come quantità di acido nucleico di A. mellea già particolarmente elevata rispetto alle altre tesi a confronto. I risultati lasciano intuire dati e differenze ancora più importanti nei prossimi anni.
Comunicazione a cura di Bio Vegetal